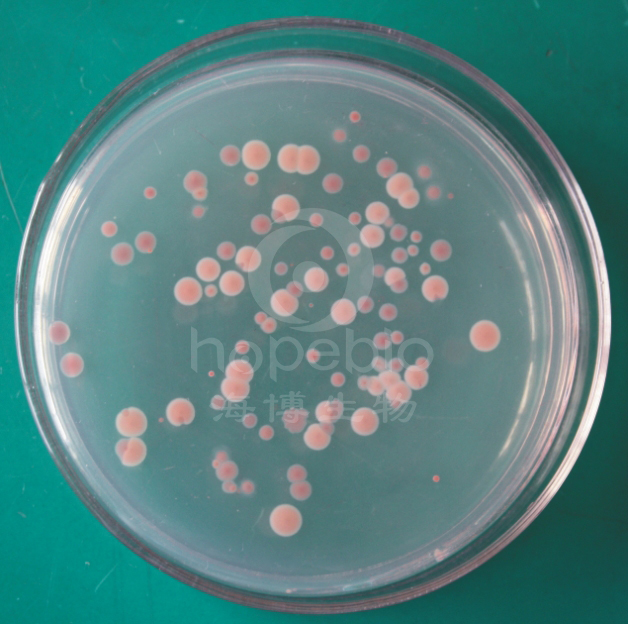
细菌总数显色平板(9cm)

万千商家帮你免费找货
0 人在求购买到急需产品
- 详细信息
- 技术资料
- 保存条件:
请置于阴凉干燥处保存
- 保质期:
三个月
- 英文名:
Total Genes Chromogenic Medium
- 库存:
100
- 供应商:
青岛海博生物
- 规格:
10个/包
细菌总数显色培养基是青岛海博生物公司改良的培养基,用于快速检测食品、水质和环境中的细菌总数。菌落显红色、淡红色。
成份(g/L)
| 特殊营养物质 | 8.4 |
| 显色剂 | 0.1 |
| 琼脂 | 15.0 |
| pH 6.9-7.1 25℃ | |
此配方可以进行改良或增加营养成份以获得最佳的结果。
操作步骤
1、按国家标准、SN标准、FDA标准或其它方法制备样品液;
2、取样品液 1ml 加入冷却至 45-50℃ 显色培养基中混匀或涂布于平板上;
3、36℃ 培养 24~48h,选用有 30~200 个菌落的平板,计数平板上出现的红色菌落(不论其大小和颜色深浅均计数)。
质量控制
1、外观
平板呈透明无色固体或淡粉色培养基。
2、微生物试验
在 36℃ 培养 24-48h:
| 质控菌株 |
ATCC |
生长情况 |
菌落颜色 |
| 单增李斯特氏菌 |
19114 |
+++ |
红色 |
| 金黄色葡萄球菌 |
25923 |
+++ |
红色 |
| 大肠埃希氏菌 |
25922 |
+++ |
红色 |
| 沙门氏菌 |
14028 |
+++ |
红色 |
| 肺炎克雷伯氏菌 |
10031 |
+++ |
红色 |
方法的局限性
本培养基用于菌落总数计数时,有些菌落可能会显无色,但都应计数在总数内。
典型特征
典型菌落为红色至淡红色。
注意
此培养基仅供实验室使用。
点击链接下载使用说明书:http://www.hopebiol.com/xiazai-download.asp?id=70
查看我公司所有显色平板菌落特征,请点击:
显色平板菌落特征细菌总数显色培养基微生物灵敏度试验:
按标签用法制备培养基,接种以下质控菌株,放置36±1℃需氧培养24-48小时。
注:回收率计算时,用TSA琼脂做对照培养基。
风险提示:丁香通仅作为第三方平台,为商家信息发布提供平台空间。用户咨询产品时请注意保护个人信息及财产安全,合理判断,谨慎选购商品,商家和用户对交易行为负责。对于医疗器械类产品,请先查证核实企业经营资质和医疗器械产品注册证情况。
技术资料暂无技术资料 索取技术资料









